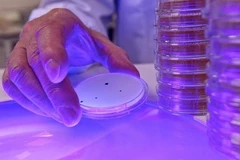
Điều trị bệnh lao kháng thuốc bằng tế bào gốc tủy xương

Hội nghị tiêu điểm của Hội Huyết học Mỹ lần đầu diễn ra tại Việt Nam
Hội Huyết học Mỹ là hội chuyên khoa lớn nhất trên thế giới với hơn 18.000 thành viên đến từ gần 100 quốc gia, bao gồm các bác sỹ lâm sàng, các nhà khoa học hoạt động trong lĩnh vực điều trị bệnh máu.